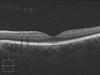
Оптическая когерентная томография в диагностике влажной формы макулярной дегенерации и диабетического макулярного отека

Similar presentations:
Возрастная макулярная дегенерация
1. ВОЗРАСТНАЯ МАКУЛЯРНАЯ ДЕГЕНЕРАЦИЯ
Подготовил:Студент 6 курса 56 группы
Шустов Дмитрий Александрович
2.
ОпределениеВозрастная макулярная
дегенерация– прогрессирующее
заболевание, характеризующееся
поражением макулярной зоны
(центральной зоны сетчатки в
заднем полюсе глазного яблока).
3. Факторы риска
• Возраст старше 65 лет• Артериальная гипертензия, атеросклеротическое
поражение сосудов (особенно сонных артерий),
высокий уровень холестерина в крови, СД,
избыточная масса тела.
• Курение.
• Избыточное воздействие солнечного света.
• Женщины в период менопауз из-за снижения
защитного действия эстрогенов
• Генетическая предрасположенность
• Пациенты, перенесшие удаление катаракты
4.
ЭтиопатогенезОкислительный стресс
Дисбаланс в системе
образования
свободных радикалов
и антиоксидантной
защиты
повреждение тканей
глаза
5.
Чувствительность сетчатки к продуктам окислительного стресса и свободнымрадикалам определяется тремя основными факторами:
1. Сетчатка постоянно подвергается сочетанному воздействию света и кислорода,
что создает идеальные условия для синтеза свободных радикалов.
2. Она содержит в большом количестве полиненасыщенные жирные кислоты,
которые наиболее чувствительны к окислению.
3. Сетчатка, как производное нервной ткани, особенно чувствительна к гипоксии.
Защита сетчатки от фотоповреждения обеспечивается за счет постоянного
обновления светочувствительного наружного сегмента фоторецепторной клетки,
системы антиоксидантной защиты и светофильтрующей системы глаза (роговица,
хрусталик, макулярный пигмент, меланин).
Ослабление или нарушение любого из звеньев этой тонко сбалансированной
защитной системы ведет к дистрофическим изменениям в сетчатке.
6.
КлассификацияКлассификация ВМД строится в основном на этапах развития
дистрофического процесса. Кацнельсон Л.А. с соавт. различают 3
формы заболевания :
1. Неэкссудативная (сухая) форма: ретинальные друзы,
дефекты пигментного эпителия, перераспределение пигмента,
атрофия пигментного эпителия и хориокапиллярного слоя.
2. Экссудативная (влажная) форма
3. Рубцовая стадия.
7. Выделяют раннюю и позднюю стадию
• Ранняя стадия. Характерны фокальные друзы инеравномерность пигментации ПЭС.
• Поздняя стадия. Характерны отслойка ПЭС, разрыв
ПЭС, хориоидальная неоваскуляризация, дисковидный
(фиброваскулярный) рубец, географическая атрофия
ПЭС.
8. Патологический очаг
Считается, что основными точкамиприложения патологического процесса
при инволюционном поражении
макулярной области являются
пигментный эпителий сетчатки,
хориокапиллярный слой сосудистой
оболочки и мембрана Бруха. Последняя
служит естественным барьером между
пигментным эпителием сетчатки и
хориокапиллярами.
9. Неэкссудативная (сухая) форма
Основными офтальмоскопическимипризнаками являются исчезновение
макулярного рефлекса, появление друз и
участков перераспределения пигмента в
заднем полюсе глаза, атрофия пигментного
эпителия и хориокапиллярного слоя.
Друзы – это внеклеточные отложения эозинофильного материала между
внутренним коллагеновым слоем мембраны Бруха и базальной мембраной
пигментного эпителия сетчатки. Можно выделить твердые, мягкие и сливные
друзы.
10.
Твердые друзы видны как мелкие, желтоватые,четко очерченные очажки на глазном дне. Их
считают относительно благоприятным
проявлением процесса, однако их наличие в
большом количестве может создать
предрасположенность к появлению мягких друз и
более тяжелых проявлений макулярной
дегенерации.
Мягкие друзы имеют большие размеры и обычно
нечеткие границы.
Сливаясь, они могут вызывать отслойку
пигментного эпителия сетчатки, атрофию
наружных слоев сетчатки и хориокапиллярного
слоя.
11.
• Сливные друзы часто приводят к обширным атрофическим изменениям(географическая атрофия) и предрасполагают к развитию
субретинальной неоваскуляризации.
• Географическая атрофия ПЭС — На глазном дне очаги географической
атрофии выявляются в виде чётко очерченных зон депигментации с
хорошо различимыми крупными хориоидальными сосудами. При этом
страдает не только ПЭС, но и наружные слои сетчатки и
хориокапиллярный слой в этой зоне.
• Перераспределение пигмента в макулярной зоне связано с
пролиферацией клеток пигментного эпителия, накоплением в них
меланина или миграцией меланинсодержащих клеток в
субретинальное пространство.
Возрастная макулярная дегенерация. Географическая атрофия:
а– цветная фотография;
б– флюоресцентная ангиография;
в– оптическая когерентная
томография
12.
Экссудативная (влажная) формаПод «влажной» формой понимают прорастание новообразованных сосудов, берущих свое начало
во внутренних слоях хориоидеи, через мембрану Бруха в пространство между пигментным
эпителием и сетчаткой, которое в норме отсутствует. Субретинальная неоваскуляризация, как
правило, сопровождается серозной отслойкой нейро- и пигментного эпителия сетчатки, отеком
сетчатки и кровоизлияниями. Офтальмоскопически серозная отслойка нейроэпителия
характеризуется появлением проминирующего очага, имеющего дисковидную форму и нечеткие
границы. В отличие от нее отслойка пигментного эпителия сетчатки имеет четкие контуры.
13. Обследование
Определение остроты зрения с оптимальной коррекцией. Оценка центрального поля зрения.Оценка цветоощущения при помощи таблиц Юстовой или Рабкина.
Биомикроскопия переднего отдела глазного яблока, измерение ВГД.
Офтальмоскопическая оценка состояния глазного дна, включая макулярную зону сетчатки (после
расширения зрачка кратковре-менно действующими мидриатиками).
Документирование состояния макулы, предпочтительно с помощью цветного стереофотографирования
глазного дна.
Выполнение флюоресцентной ангиографии и/или ангиографии с
Индоцианин зелёным.
При подозрении на наличие отёка сетчатки рекомендуется вы-полнить оптическую когерентную
томографию или исследование макулярной зоны при помощи Гейдельбергского
ретинальноготомографа (HRT II).
Электрофизиологические исследования (ганцфельд-ЭРГ, ритми-ческая ЭРГ, паттерн-ЭРГ,
мультифокальная ЭРГ).
14. Лазерное лечение
Лазерное лечение ВМД, сопровождающейся развитиемсубретинальной неоваскуляризации, предполагает
использование трех основных методов:
• лазеркоагуляция субретинальных мембран;
• фотодинамическая терапия;
• транспупиллярная термотерапия.
15.
Флюоресцентная ангиография иоптическая когерентная томография
пациента с «влажной» формой
возрастной макулярной
дегенерации, сопровождающейся
классической хориоидальной
неоваскуляризацией до (а–в) и
после (г–е) лазерной коагуляции
субретинальной мембраны
16.
Фотодинамическая терапияМетодика предусматривает использование
вертепорфина– вещества, которое активируется в
результате светового воздействия. При внутривенном
введении вертепорфин быстро поступает к очагу
поражения и селективно захватывается эндотелием
новообразованных сосудов неоваскулярной мембраны.
Облучение новообразованных сосудов осуществляется
при помощи диодного лазера с длиной волны 689 нм.
Лазерная энергия свободно проходит через кровь,
меланин и фиброзную ткань, не подвергая
неблагоприятному воздействию окружающую сетчатку.
Под действием нетеплового лазерного излучения
вертепорфин генерирует свободные радикалы, которые
повреждают эндотелий новообразованных сосудов. В
результате происходит тромбоз и облитерация сосудов
субретинальной мембраны.
17.
Транспупиллярная термотерапияМетод заключается в подпороговом
воздействии лазерного излучения на зону
поражения. Используются диодные лазеры с
длиной волны 810 нм. Показанием для
выполнения термотерапии является скрытая
хориоидальная неоваскуляризация или
субретинальные неоваскулярные мембраны с
минимальным классическим компонентом.
Однако большой процент осложнений,
связанных в первую очередь с передозировкой
лазерной энергии, привел к тому, что сегодня
транспупиллярная термотерапия практически
не применяется для лечения ВМД.
18. Хирургическое лечение
• Удаление субретинальных неоваскулярных мембран. Показанием для операцииявляется наличие классической хориоидальной неоваскуляризации с чёткими
границами.
• Удаление массивных субретинальных кровоизлияний.
• Пересадка клеток пигментного эпителия.
• Транслокация макулы— возможная альтернатива фотодинамической терапии
или лазеркоагуляции по поводу субфовеальных неоваскулярных мембран.
Основная идея такого вмешательства состоит в том, чтобы сместить
расположенный над хориоидальной неоваскулярной мембраной
нейроэпителий фовеальной зоны сетчатки так, чтобы в новом положении под
ним находились неизменённый ПЭС и хориокапиллярный слой.
19. Медикаментозное лечение
В настоящее время не существуеттерапевтических воздействий с
доказанной эффективностью при ВМД.
При «сухой форме» лекарственная
терапия направлена на профилактику
формирования друз и отложений
липофусцина, а при экссудативной форме
— призвана препятствовать
патологическому ангиогенезу.
20.
• Антиоксиданты - Окувайт Лютеин, Лютеинкомплекс, экстракт черники («Миртиленефорте»).
• Ингибиторы ангиогенеза - Пегаптаниб (макутен),
Ранибицумаб (RhuFabV2)
• Кортикостероиды – Анекортав, Триамцинолон
Оптическая когерентная томография пациента с
«влажной» формой возрастной макулярной
дегенерации до (а) и после (б) интравитреального
введения ингибиторов ангиогенеза
21. Прогноз
У больных при отсутствии терапии значительного снижения остроты зрения в срок от 6 месдо 5 лет можно ожидать в 60—65% случаев. Часто поражение является двусторонним и
может приводить к инвалидности по зрению.
Целью лечебных воздействий при ВМД при наличии хориоидальных неоваскулярных
мембран является достижение стабилизации патологического процесса, а не улучшение
зрения.
Лазеркоагуляция и транспупиллярная термотерапия позволяют сократить количество
случаев тяжёлой утраты зрения до 23—46% случаев (в зависимости от локализации
процесса), фотодинамическая терапия с вертепорфином — в среднем до 40%,
субмакулярная хирургия — до 19%.






















 medicine
medicine